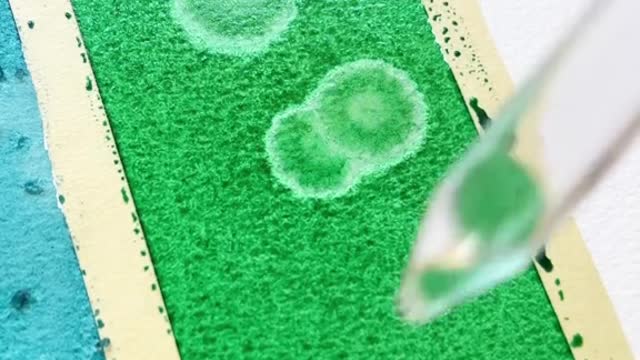

Premium Only Content
This video is only available to Rumble Premium subscribers. Subscribe to
enjoy exclusive content and ad-free viewing.
black guy in
Loading comments...
-
 12:05
12:05
Clintonjaws
5 hours ago $1.57 earnedPortland ICE Rioters Getting Arrested - This Is Priceless!
2.92K4 -
 2:25:56
2:25:56
Steven Crowder
5 hours agoCandace Just Claimed Trump Killed Charlie
311K412 -
 LIVE
LIVE
Robert Gouveia
2 hours agoNewsom Crushed AGAIN!! NBA Arrests! NEW Pipe Bomber Info! Melania SUED!
560 watching -
 59:41
59:41
Sean Unpaved
2 hours agoHoops & Handcuffs: FBI's Mafia Takedown in NBA Betting Scandal
3.45K -
 LIVE
LIVE
Side Scrollers Podcast
1 hour ago🔴FIRST EVER RUMBLE SUB-A-THON🔴DAY 4🔴WAKE YOUR ASS UP!
962 watching -
 1:07:10
1:07:10
Rebel News
1 hour agoCarney's lacklustre speech, Libs partner with China, How many illegals in Canada? | Rebel Roundup
3.97K2 -
 41:55
41:55
The Rubin Report
3 hours agoListen to ‘The View’ Crowd Gasp as Whoopi Lies to Their Faces
84.2K47 -
 1:41:47
1:41:47
The Mel K Show
3 hours agoMORNINGS WITH MEL K - Cause and Effect: The Intentional Dumbing Down of a Nation - 10-23-25
25.1K3 -
 LIVE
LIVE
ReAnimateHer
1 day ago $0.20 earnedFIRST Live Stream Rusty Hookin
18 watching -

The Shannon Joy Show
5 hours ago🔥SJ Show 10/23 * Rep Tom Massie LIVE On Trump’s Beef Rancher Rug Pull * Civil Unrest Incoming * How To Prepare W/ Brett Miller 🔥
11.6K7